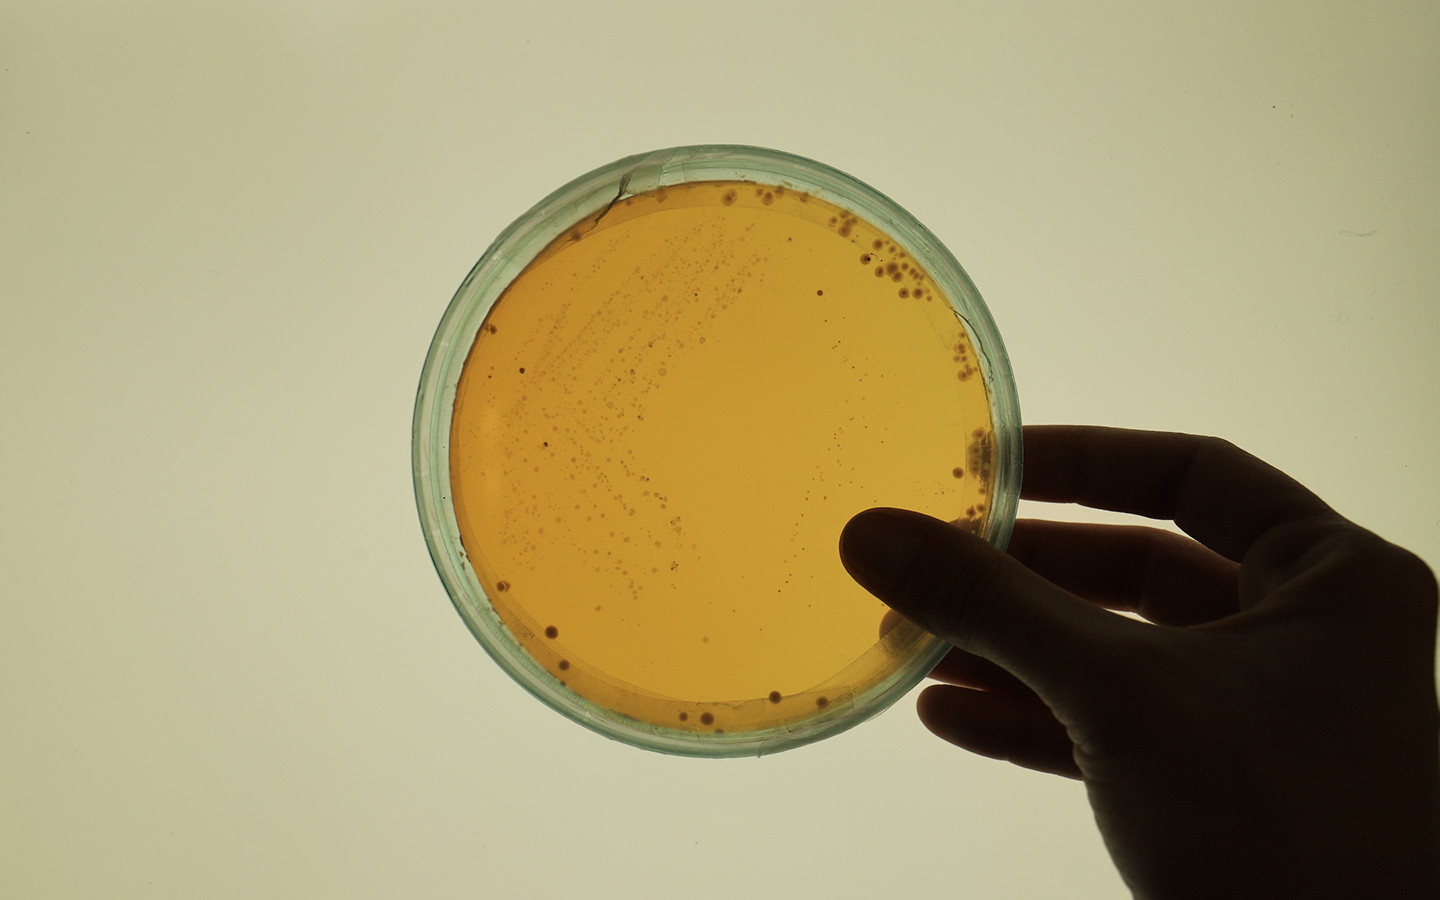
The Soothing Cup

The Soothing Cup
Una relación mutua con una copa menstrual viva
The Soothing Cup se compone de una copa menstrual y una incubadora. Un hidrogel a base de algas convierte la copa en una biomembrana que puede interactuar con el entorno vaginal, mientras que la incubadora permite a las usuarias cultivar sus propias bacterias antiinflamatorias en sus copas menstruales personales para reducir las molestias del periodo. El nivel de cuidado requerido en este ritual crea una conexión íntima entre la menstruante y la copa, reduciendo el deseo de comprar productos de higiene de un solo uso y desafiando el estigma social en torno a los períodos.
Empresa/Institución
UAL - Central Saint Martins
MA Biodesign at Central Saint Martins
The course will introduce designers from multidisciplinary design backgrounds to whole system thinking, biomimicry principles, biological systems, bio-computational design, digital and bio-fabrication techniques. You will apply these principles to designing new sustainable materials, products, services, systems and architectural propositions. There is a strong emphasis on ethical issues and on learning through making. Theoretical, global cultural and socio-environmental contexts will inform the development of your personal biodesign agenda.

País
Reino Unido
Designer(s)
Lucrezia Alessandroni

Lucrezia Alessandroni is a biodesigner with a background in product design and visual communication. Her previous passions for sustainability, wearables and open-source technologies drove her to explore the interconnections among living organisms and ecosystems. Her research focuses on female healthcare and living objects as a tool to develop new symbiotic relationships with micro and macro environments.